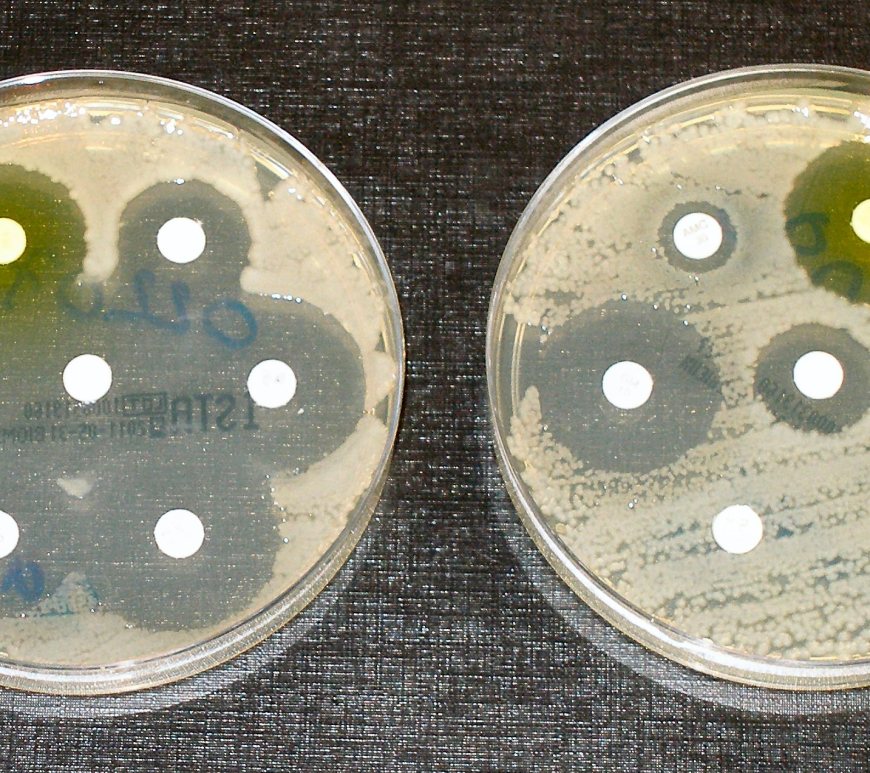
Figure 1. Researchers investigate a new way of preventing the spread of antibiotic resistant genes among bacteria to slow their rapid increase.

Stopping the Transfer of Antibiotic Resistant Genes
By Meghan Bialt-DeCelie ‘19 The overuse of antibiotics is causing rapid increase in antibiotic resistant bacteria. Through a type IV secretion system, bacteria that aren’t killed by the antibiotics share their antibiotic resistant genes with other bacterial cells via bacterial conjugation. Researchers have been looking for a way to slow down the growing resistance. A study led by Dr. Bastien Casu from Université de Montréal … Continue reading Stopping the Transfer of Antibiotic Resistant Genes

